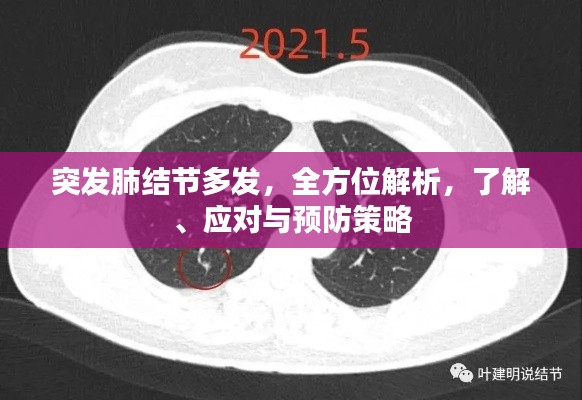
突发肺结节多发，全方位解析，了解、应对与预防策略

在现今社会,随着医疗技术的进步和人们健康意识的提高,越来越多的疾病被早期发现,其中包括肺部疾病。“突发多个肺结节”这一病症也逐渐引起公众的关注,今天我们就来详细解析这一病症,帮助大家了解、应对与预防。
了解突发多个肺结节
肺结节是指肺部出现的圆形或类圆形的高密度影,可以单发,也可以多发,大多数肺结节是良性的,但部分需要警惕恶性可能,突发多个肺结节则是指在短时间内,肺部突然出现多个结节,这种情况可能是肺部感染、炎症、结核或肿瘤等疾病的表现。
如何应对突发多个肺结节
1、保持冷静:遇到突发多个肺结节的情况,首先要保持冷静,不要恐慌。
2、及时就医:尽快到医院进行进一步检查,如CT、MRI等,以明确结节的性质。
3、听从医生建议:根据医生的建议,进行针对性的治疗。
4、保持良好的生活习惯:戒烟、避免长时间暴露在空气污染环境中,保持良好的饮食习惯和适当的运动。
如何预防突发多个肺结节
1、戒烟:戒烟是预防肺部疾病的有效手段,包括突发多个肺结节。
2、避免长时间暴露在空气污染环境中:空气污染是导致肺部疾病的重要因素之一,因此要尽量避免长时间暴露在空气污染环境中。
3、保持良好的生活习惯:保持充足的睡眠,均衡的饮食,适当的运动,有助于增强身体免疫力,预防疾病的发生。
4、定期体检:定期进行体检,特别是针对肺部的检查,有助于早期发现疾病,及时进行治疗。
案例分析
张先生,45岁,平时身体健康,无任何不适,在一次体检中,突然发现多个肺结节,经过进一步检查,确诊为早期肺癌,由于发现及时,经过手术治疗和术后康复,张先生的病情得到了有效控制,这个案例告诉我们,定期进行体检,早期发现疾病,对于疾病的治疗和康复至关重要。
突发多个肺结节虽然是一种较为严重的病症,但只要我们了解其性质,采取正确的应对措施,并加强预防,就能有效地保护我们的健康,戒烟、避免长时间暴露在空气污染环境中、保持良好的生活习惯和定期体检,是预防突发多个肺结节的有效方法,我们也要保持积极的心态,勇敢面对疾病,积极配合医生的治疗建议,共同抗击疾病,希望通过本文的解析,能帮助大家更好地了解、应对与预防突发多个肺结节这一病症。
转载请注明来自无锡市先进制造产业知识产权运营服务平台,本文标题:《突发肺结节多发,全方位解析,了解、应对与预防策略》

苏ICP备2021053023号-1
苏ICP备2021053023号-1
还没有评论,来说两句吧...